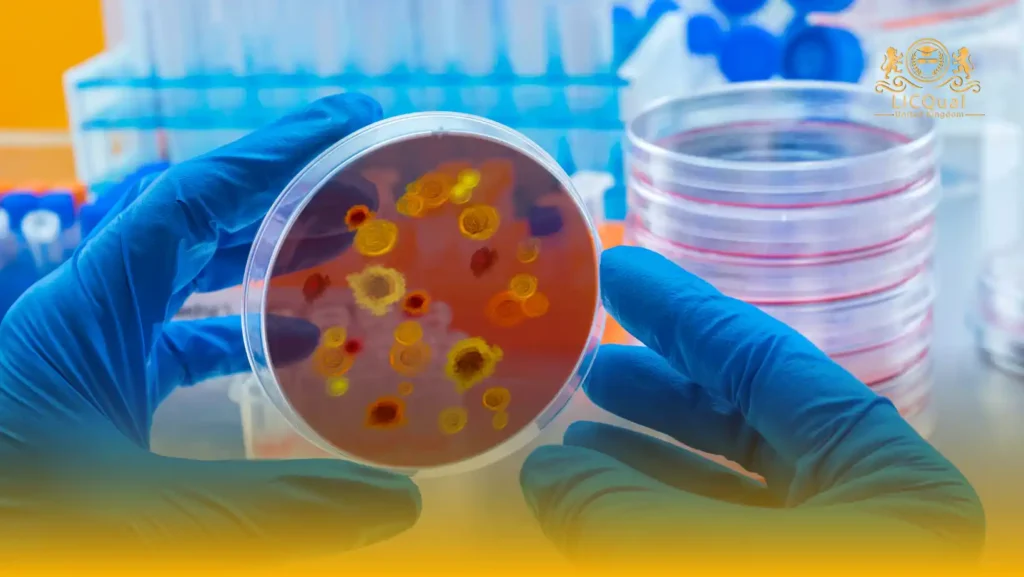
LICQual Level 3 Certificate in Nutritional Epidemiology (Cert Nutritional Epidemiology)
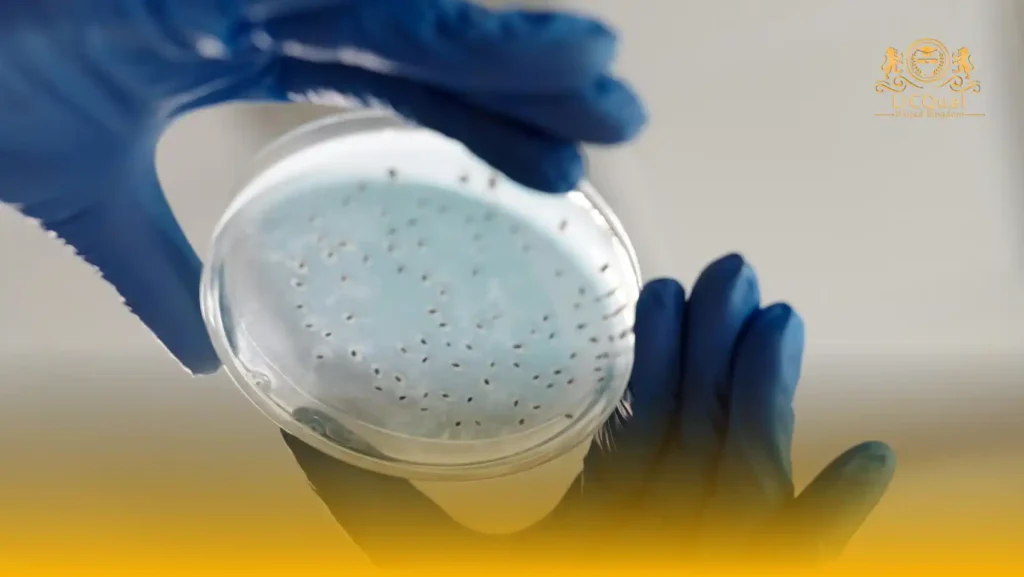
LICQual Level 3 Diploma in Nutritional Epidemiology (Dip Nutritional Epidemiology)

In today’s world, where health and wellness are at the forefront, Nutrition and Dietetics has become one of the most in-demand and rewarding fields of study. These courses focus on understanding how food, nutrients, and lifestyle choices affect human health, and how diet can be used to prevent or manage diseases.
Whether you’re passionate about fitness, healthcare, or helping others live healthier lives, studying Nutrition and Dietetics opens doors to a wide range of career opportunities in hospitals, wellness centers, research institutions, and the food industry.
A Nutrition and Dietetics course is more than just learning about food — it’s about empowering individuals and communities to live healthier, longer, and happier lives. As lifestyle diseases continue to rise worldwide, the demand for qualified nutrition experts has never been greater.